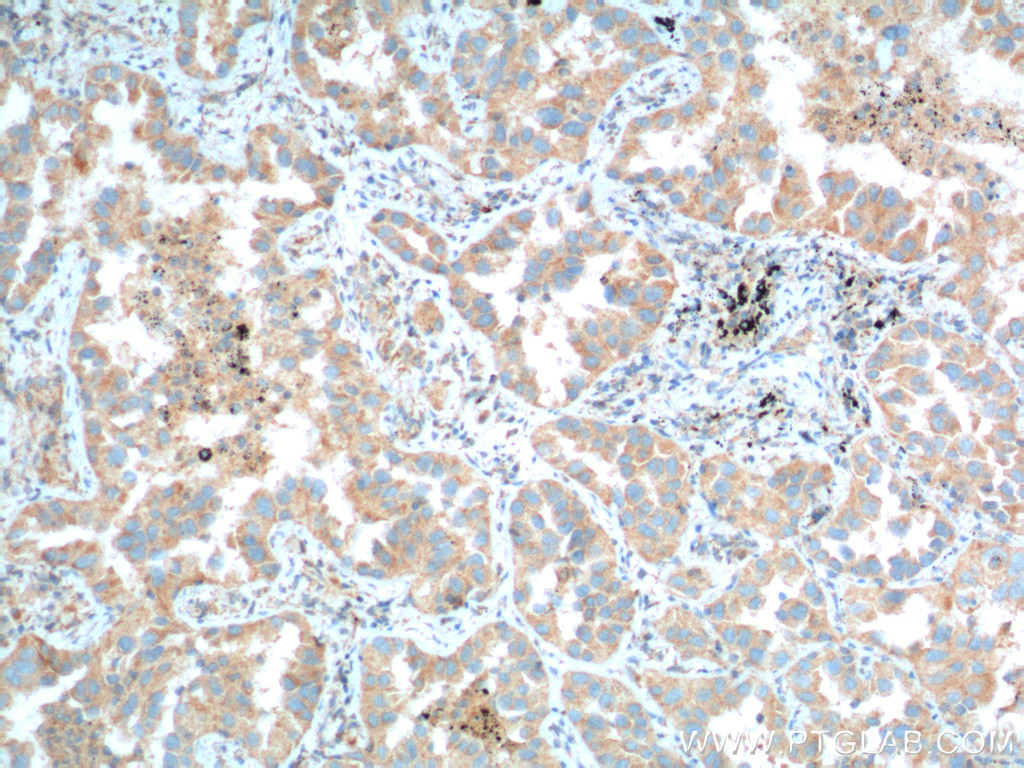

验证数据展示
经过测试的应用
| Positive WB detected in | mouse brain tissue, rat brain tissue |
| Positive IHC detected in | human lung cancer tissue, human skeletal muscle tissue, mouse brain tissue Note: suggested antigen retrieval with TE buffer pH 9.0; (*) Alternatively, antigen retrieval may be performed with citrate buffer pH 6.0 |
| Positive IF/ICC detected in | HeLa cells |
推荐稀释比
| 应用 | 推荐稀释比 |
|---|---|
| Western Blot (WB) | WB : 1:1000-1:4000 |
| Immunohistochemistry (IHC) | IHC : 1:50-1:500 |
| Immunofluorescence (IF)/ICC | IF/ICC : 1:250-1:1000 |
| It is recommended that this reagent should be titrated in each testing system to obtain optimal results. | |
| Sample-dependent, Check data in validation data gallery. | |
产品信息
60094-2-Ig targets PFN2 in WB, IHC, IF/ICC, ELISA applications and shows reactivity with human, mouse, rat, pig samples.
| 经测试应用 | WB, IHC, IF/ICC, ELISA Application Description |
| 文献引用应用 | WB, IHC, IF |
| 经测试反应性 | human, mouse, rat, pig |
| 文献引用反应性 | human, mouse |
| 免疫原 |
CatNo: Ag5043 Product name: Recombinant human PFN2 protein Source: e coli.-derived, PET28a Tag: 6*His Domain: 1-140 aa of BC018049 Sequence: MAGWQSYVDNLMCDGCCQEAAIVGYCDAKYVWAATAGGVFQSITPIEIDMIVGKDREGFFTNGLALGAKKCSVIRDSLYVDGDCTMDIRTKSQGGEPTYNVAVGRAGRVLVFVMGKEGVHGGGLNKKAYSMAKYLRDSGF 种属同源性预测 |
| 宿主/亚型 | Mouse / IgG2a |
| 抗体类别 | Monoclonal |
| 产品类型 | Antibody |
| 全称 | profilin 2 |
| 别名 | Prifilin 2, Profilin II, profilin 2, PFL, D3S1319E |
| 计算分子量 | 140 aa, 15 kDa |
| 观测分子量 | 15 kDa |
| GenBank蛋白编号 | BC018049 |
| 基因名称 | PFN2 |
| Gene ID (NCBI) | 5217 |
| RRID | AB_2163215 |
| 偶联类型 | Unconjugated |
| 形式 | Liquid |
| 纯化方式 | Protein A purification |
| UNIPROT ID | P35080 |
| 储存缓冲液 | PBS with 0.02% sodium azide and 50% glycerol, pH 7.3. |
| 储存条件 | Store at -20°C. Stable for one year after shipment. Aliquoting is unnecessary for -20oC storage. |
背景介绍
PFN2 (profilin 2) is a ubiquitous actin monomer-binding protein belonging to the profilin family. It is thought to regulate actin polymerization in response to extracellular signals. The MW of this protein is 15 kDa, and this antibody specially recognises the 15 kDa protein.
实验方案
| Product Specific Protocols | |
|---|---|
| IF protocol for PFN2 antibody 60094-2-Ig | Download protocol |
| IHC protocol for PFN2 antibody 60094-2-Ig | Download protocol |
| WB protocol for PFN2 antibody 60094-2-Ig | Download protocol |
| Standard Protocols | |
|---|---|
| Click here to view our Standard Protocols |
发表文章
| Species | Application | Title |
|---|---|---|
Elife Synaptic pruning in the female hippocampus is triggered at puberty by extrasynaptic GABAA receptors on dendritic spines. | ||
J Cell Biol NCAM regulates temporal specification of neural progenitor cells via profilin2 during corticogenesis.
| ||
Int J Oncol Loss of profilin 2 contributes to enhanced epithelial-mesenchymal transition and metastasis of colorectal cancer. | ||
Front Mol Neurosci Integrated proteomics and metabolomics analysis of D-pinitol function during hippocampal damage in streptozocin-induced aging-accelerated mice | ||
Mol Med ets1 associates with KMT5A to participate in high glucose-mediated EndMT via upregulation of PFN2 expression in diabetic nephropathy.
| ||
J Mammary Gland Biol Neoplasia Circ_0008500 Knockdown Improves Radiosensitivity and Inhibits Tumorigenesis in Breast Cancer Through the miR-758-3p/PFN2 Axis. |